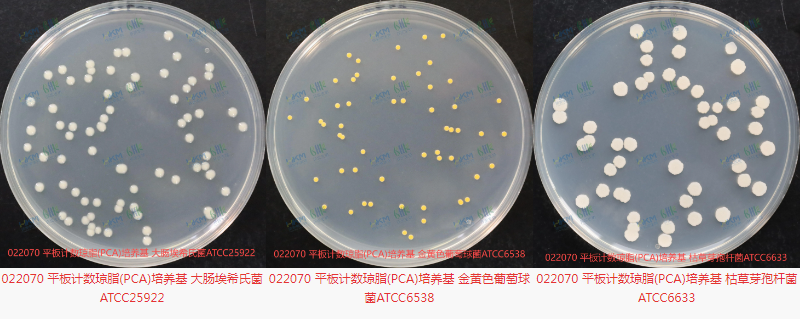
19944611.png

022070 平板计数琼脂(PCA)培养基
发布时间 :2025-05-22 发布人:yumiaoshengwu 浏览量:递增失败!
产品名称:平板计数琼脂(PCA)培养基
产品货号:022070
生产厂家:广东环凯
产品规格:250g / 瓶,颗粒型
产品用途:主要用于菌落总数测定,适用于检测各类样品中的需氧菌数量,如食品、饮料、药品、化妆品、环境样本等中的细菌总数。
储存条件:避光、干燥。
保质期:未开封保质期三年。
检验原理:胰蛋白胨提供碳源和氮源,满足细菌生长所需的营养;酵母膏粉提供 B 族维生素,有助于细菌的代谢和生长;葡萄糖作为能源物质,为细菌的生命活动提供能量;琼脂是培养基的凝固剂,使培养基在常温下保持固态,便于细菌在其表面生长形成菌落。
产品成分:每升培养基中含有胰蛋白胨 5.0g、酵母膏粉 2.5g、葡萄糖 1.0g、琼脂 15.0g,最终 pH 值为 7.0±0.2。
储存条件:避光、干燥。
保质期:未开封保质期三年。
使用方法:称取本品 23.5g,加入蒸馏水或去离子水 1L,搅拌加热煮沸至完全溶解,分装三角瓶,121℃高压灭菌 15min。待培养基冷却至适当温度后,可用于接种稀释和处理后的样品。
质量控制
质控菌株:接种大肠埃希氏菌 ATCC25922、金黄色葡萄球菌 ATCC6538、枯草芽孢杆菌 ATCC6633 等质控菌株。
生长率要求:在 35~37℃培养 48±2h 后,各菌株的生长率 PR≥0.7。
特征性反应:大肠埃希氏菌形成灰白色菌落,金黄色葡萄球菌形成黄色菌落,枯草芽孢杆菌形成灰白色菌落。

产品特点
原料优质:核心原料从欧洲进口,质量稳定,批次间差异小,培养基溶液清澈明亮,颜色均匀。
质控严格:从原料到成品的整个过程都受到严格监控,确保产品的高质量和稳定性。
工艺先进:采用先进的 granulation 工艺,不添加任何 coagulant,不会影响微生物的生长。
注意事项:称量时注意粉尘,佩戴口罩操作以避免引起呼吸道系统不适。



